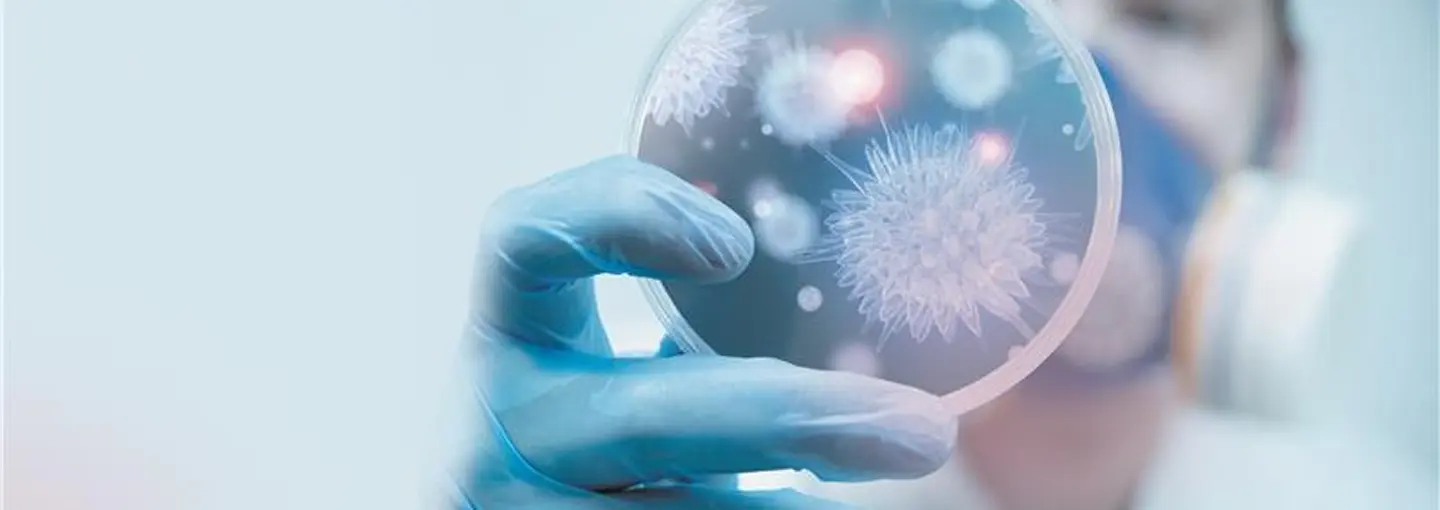

Recherchez un document, une référence, un article...
Et si vous formuliez votre recherche ? Vous pouvez aussi pour parcourir nos gammes produits.
Prestations de service
La désinfection et la protection des réseaux sanitaires
notre accompagnement
BWT vous accompagne sur les actions de désinfection
Elle permet également de sécuriser les installations, en réduisant les arrêts techniques imprévus et le besoin d'opérations curatives, ce qui entraîne une diminution des coûts de maintenance. De plus, la désinfection contribue à vous mettre en conformité avec la législation afin d’éviter d’engager votre responsabilité.
3 étapes pour une désinfection réussie
Diagnostic
Conception d’une offre technique et commerciale. Protocole opératoire sur-mesure
- Transmission des informations techniques : contexte, résultats d’analyse.
- Coordination avec vos équipes.
- Relevé de chantier.
- Préconisation des mesures d’urgence en cas de contamination avérées.
Prestation de désinfection
Conception d’une offre technique et commerciale. Protocole opératoire sur-mesure
- Transmission des informations techniques : contexte, résultats d’analyse.
- Coordination avec vos équipes.
- Relevé de chantier.
- Préconisation des mesures d’urgence en cas de contamination avérées.
Contrôle
Conception d’une offre technique et commerciale. Protocole opératoire sur-mesure
- Transmission des informations techniques : contexte, résultats d’analyse.
- Coordination avec vos équipes.
- Relevé de chantier.
- Préconisation des mesures d’urgence en cas de contamination avérées.
Les réglementations et législations en vigueur pour la désinfection et la protection des réseaux sanitaires
En tant que propriétaire ou gestionnaire d'un bâtiment tertiaire, vous devez impérativement connaître et respecter les réglementations en vigueur concernant la désinfection et la protection des réseaux sanitaires. Ces normes sont définies par différents textes législatifs et réglementaires, qui varient selon la nature de votre bâtiment et son activité.

Ce que dit la loi et exemples de réglementations
Avant mise en service de réseaux et EFG ou après travaux
Article R1321-56 du Code de la santé publique “Les réseaux et installations doivent être nettoyés, rincés et désinfectés avant toute mise ou remise en service. Le Directeur général de l’ARS et tenu informé par la personne responsable de la production.”
De manière préventive pour les contaminations légionelles et autres bactéries
Article R1321-56 du Code de la santé publique “Les réseaux et installations doivent être vidés, nettoyés, rincés et désinfectés avant toute mise ou remise en service et les réservoirs les équipant, au moins une fois par an.”
Circulaire N°202/243 et arrêté du 1er février 2010 pour les ERP “Le responsable des installations met en œuvre une surveillance de ses installations afin de vérifier que les seuils sont respéctés en permanence au niveau de tous les points d’usage à risque.
Curative en cas de contaminations avérées : EFG, ECS, TAR, sur réseaux techniques
Circulaire N°2002/243 et arrêté du 1er Février 2010 pour les ERP “Les dénombrements en Legionella Pneumophila doivent être inférieurs à 1000 unités formantes colonie par litre au niveau de tous les points d’usage à risque, et inférieurs au seuil de détection dans les établissements de santé”
“Lorsque ces seuils ne sont pas respectés, le responsable des installations prend sans délai les mesures correctives nécessaires au rétablissement de la qualité de l’eau et à la protection des usagers.”
Le saviez-vous ?
70% des ECS collectifs ne seraient pas en conformité en cas de mise en service d’une installation neuve ou après travaux ! Le non-respect de ces réglementations peut entraîner des sanctions administratives ou pénales, telles que des amendes, des mises en demeure ou la fermeture temporaire de votre bâtiment. Il est donc essentiel de vous conformer à ces obligations légales pour éviter tout risque.
Proposez à vos clients de prendre directement rendez-vous sur bwt-monservice.com pour la mise en service. C'est simple, rapide et efficace !
Pour maintenir une protection efficace
Au-delà des obligations réglementaires, il est essentiel de mettre en place des bonnes pratiques pour maintenir une désinfection et une protection efficace de vos réseaux sanitaires dans le collectif tertiaire. Ces bonnes pratiques permettent de prévenir les risques de contamination et de garantir la salubrité de vos installations sur le long terme. Quelques exemples de bonnes pratiques à adopter :
La formation et la sensibilisation du personnel
Formez votre personnel aux bonnes pratiques d'hygiène et de maintenance des réseaux sanitaires. Sensibilisez-les aux risques liés à une mauvaise désinfection ou à une protection insuffisante.
L'entretien régulier
Mettez en place un programme d'entretien régulier pour vos installations sanitaires. Cela comprend le nettoyage, la désinfection, le remplacement des pièces défectueuses et la vérification du bon fonctionnement des équipements.
La gestion des travaux
Lors de travaux ou de modifications sur vos réseaux sanitaires, prenez les précautions nécessaires pour éviter tout risque de contamination. Faites appel à BWT et respectez les protocoles de désinfection et de remise en service.
La traçabilité
Tenez à jour un registre détaillé de toutes les opérations de désinfection, de contrôle et de maintenance effectuées sur vos réseaux sanitaires. Cette traçabilité est essentielle pour démontrer votre conformité aux réglementations en vigueur.
En adoptant ces bonnes pratiques, vous contribuerez non seulement à préserver la santé des occupants de votre bâtiment, mais également à assurer la pérennité et la conformité de vos installations sanitaires.
Les contrôles et les tests pour assurer la conformité de vos réseaux sanitaires
Une fois les mesures de désinfection et de protection mises en place, il est essentiel de procéder à des contrôles et des tests réguliers pour s'assurer de leur efficacité et de la conformité de vos installations sanitaires. Ces contrôles permettent de détecter rapidement des risques potentiels et de prendre les mesures correctives nécessaires.
La fréquence de ces contrôles et tests peut varier en fonction de la nature de votre bâtiment, de son activité et des risques identifiés lors du diagnostic initial. Il est recommandé de suivre les préconisations des experts BWT et des autorités compétentes pour définir un programme de contrôles adapté à votre situation.

BWT Pro Mag
Tous nos conseils, astuces et tutoriels pour un traitement de l’eau réussi !


